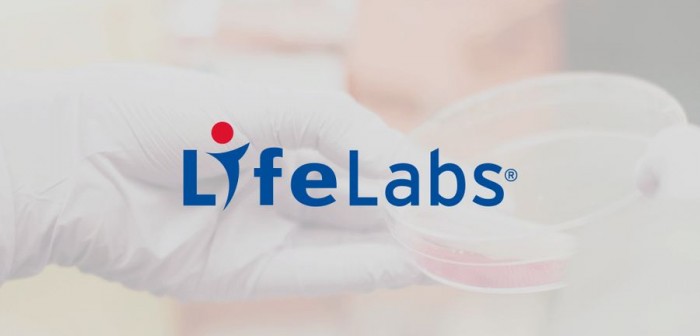

信息来源:cnBeta
LifeLabs是一家位于加拿大、业内领先的医疗诊断和测试服务提供商。今天该公司宣布向黑客支付赎金,以赎回上月安全泄露事件中被窃取的数据和资料。在新闻稿中写道:“通过熟悉网络攻击和谈判的网络专家,我们和这些网络犯罪分子进行交易。”
目前尚不清楚公司为恢复这些数据支付了多少费用。外媒ZDNet通过电话联系LifeLabs发言人时,表示不会立即对此事发表评论。LifeLabs此前表示本次泄露事件覆盖加拿大将近半数人口,超过1500万人的资料可能已经泄露。
多数受影响客户在安大略省(Ontario)和卑诗省(British Columbia)。LifeLabs 指出,安全专家经过调查,包括监视暗网和其他网络地址,并未看到任何客户资料遭公开披露。
安大略省、卑诗省的资安专员毕米希(Brian Beamish)和麦克沃伊(Michael McEvoy)表示,他们在11 月1 日已被告知这起事件,现正联合进行调查,称攻击规模“非常令人担忧”。




